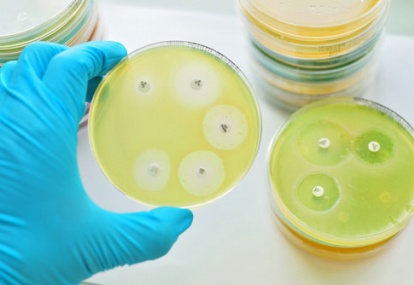

Why things will never be the same again
The GPs of Ireland have taken on without demur a load of extra work and danger. With many squirts of the sanitiser we have logged on and played a full and unreserved part in the national plan to contain the coronavirus.
We organised our practices to make it safe for patients and staff. They began to resemble...
Read more